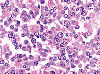

|    |

全登録症例数:225
全登録画像数:1755
全登録画像数:1755
本例は、増殖する形質芽球様細胞については、通常の骨髄腫で陽性を示すCD79a・CD56が陰性であり、CD38(+)、MUM-1(+)、EMA(+)、MIB-1L1の陽性やIgG/λ型を認めたことより形質細胞骨髄腫(形質芽球型)と診断された...
(続きを読む) 本例は、増殖する形質芽球様細胞については、通常の骨髄腫で陽性を示すCD79a・CD56が陰性であり、CD38(+)、MUM-1(+)、EMA(+)、MIB-1L1の陽性やIgG/λ型を認めたことより形質細胞骨髄腫(形質芽球型)と診断された。形質芽球性リンパ腫については全身のリンパ節腫脹がなく、病変の主座が骨髄であること、低分化型癌腫の骨転移についてはcytokeratinなどの上皮性マーカーが陰性であったことより否定された。
(たたむ)
(続きを読む) 本例は、増殖する形質芽球様細胞については、通常の骨髄腫で陽性を示すCD79a・CD56が陰性であり、CD38(+)、MUM-1(+)、EMA(+)、MIB-1L1の陽性やIgG/λ型を認めたことより形質細胞骨髄腫(形質芽球型)と診断された。形質芽球性リンパ腫については全身のリンパ節腫脹がなく、病変の主座が骨髄であること、低分化型癌腫の骨転移についてはcytokeratinなどの上皮性マーカーが陰性であったことより否定された。
(たたむ)
■症例詳細データ
| 性別 | 男 |
|---|---|
| 年齢 | 70-74 |
| 取得年代 | 2005-2009 |
| 主訴 | 頚部痛、左上肢の痺れ |
| 既往歴 | 特になし |
| 現病歴 | 1か月前より頚部痛や左上肢の異常知覚・筋力低下が出現したため当院の整形外科を受診した。MRI検査にて頚部椎体のびまん性低信号と第3頚椎椎体を中心とした腫瘍性病変を認めたため精査目的にて入院した。頚部リンパ節、肝脾腫触知せず。 PET-CT検査にて椎体や肋骨をはじめ全身の躯幹骨でびまん性のFDG異常集積を認めた。 |
| 検査所見 | WBC3,500μl (My2,Met2,St110,Seg53,Ba1,Ly27,Mo3%,other2%)、 RBC334万/μl、Hb9.8g/dl、Ht30.9%、MCV92.5fl、MCH29.3pg、MCHC31.7%、PLT9.4万/μl 、BM-dry tap TP7.0g/dl、Alb 3.4g/dl、AST41IU/l、ALT32IU/l、LDH480IU/、γ-GTP121IU/l、BUN20mg/dl、Cre1.0mg/dl、UA8.3mg/dl、CRP1.5mg/dl、PT88%、PT(INR)1.05、APTT31.5sec、Fibg436mg/dl、FDP4μg/ml、D-D2μg/ml、CEA7.9ng/ml、NSE12ng/ml、sIl-2R 2,521U/ml、IgG1770mg/dl、IgA130mg/dl、IgM16mg/dl、HIV(-)、EBV(-)、HTLV-Ⅰ(-) |
| 末梢血所見 | 白血球減少(3,500/μl)のもと幼若顆粒球の出現と異常細胞を2%認めた。異常細胞は大型でN/C比は低く、大きな核小体が顕著で細胞質は好塩基性であった。 |
| 骨髄所見 | 骨髄はdry tapで針先に付着した骨髄穿刺液を捺印した標本では、M/E比は3.35でリンパ球は31.0%みられ、形質細胞は2.0%でother34.2%を認めた。Other細胞は、好塩基性の細胞質に核周明庭を有する形質細胞様で明瞭な核小体が特徴的であった。結局、腫瘍性の形質細胞として捉え、核小体が明瞭なことより形質芽球様の増殖と思われた。 |
| 細胞化学所見 | 形質芽球様細胞はPO染色、EST染色に陰性でPAS染色にびまん性の陽性がみられた。 |
| 形態診断 | 形態学的には末梢血、骨髄にみられる形質芽球様の増加を考慮すると形質細胞骨髄腫(形質芽球型)を疑い、臨床的には椎体、肋骨や全身にFDG異常集積、IgG軽度増量、sIl-2R高値なども支持するものと思えた。またCEAやNSEの高値は腺癌や小細胞癌の骨髄転移も考えた。また、形質芽球性リンパ腫(PBL)も除外診断とした。 |
| 免疫学的所見 | 【骨髄生検-免疫染色】 CD3(-)、CD20(-)、CD79a(-)、CD56(-)、PAX-5(-)、 MuM-1(+)、IgG(+)、IgA(-)、IgM(-)、 κ鎖(-)、λ鎖(+)、p53-protein(+)、MIB-1L1(60~70%) |
| 分子生物学的所見 | N.D |
| リンパ節所見 | 【骨髄生検-HE】 過形成骨髄で、類円形核と明瞭な大型な核小体を有する大型の異常細胞がびまん性に増殖し正常造血は著しく抑制されていた。 |
| 臨床診断 | 増殖する形質芽球様細胞については、通常の骨髄腫で陽性を示すCD79a・CD56が陰性であり、CD38(+)、MUM-1(+)、EMA(+)、MIB-1L1の陽性やIgG/λ型を認めたことより形質細胞骨髄腫(形質芽球型)と診断された。形質芽球性リンパ腫については全身のリンパ節腫脹がなく、病変の主座が骨髄であること、低分化型癌腫の骨転移についてはcytokeratinなどの上皮性マーカーが陰性であったことより否定された。 |